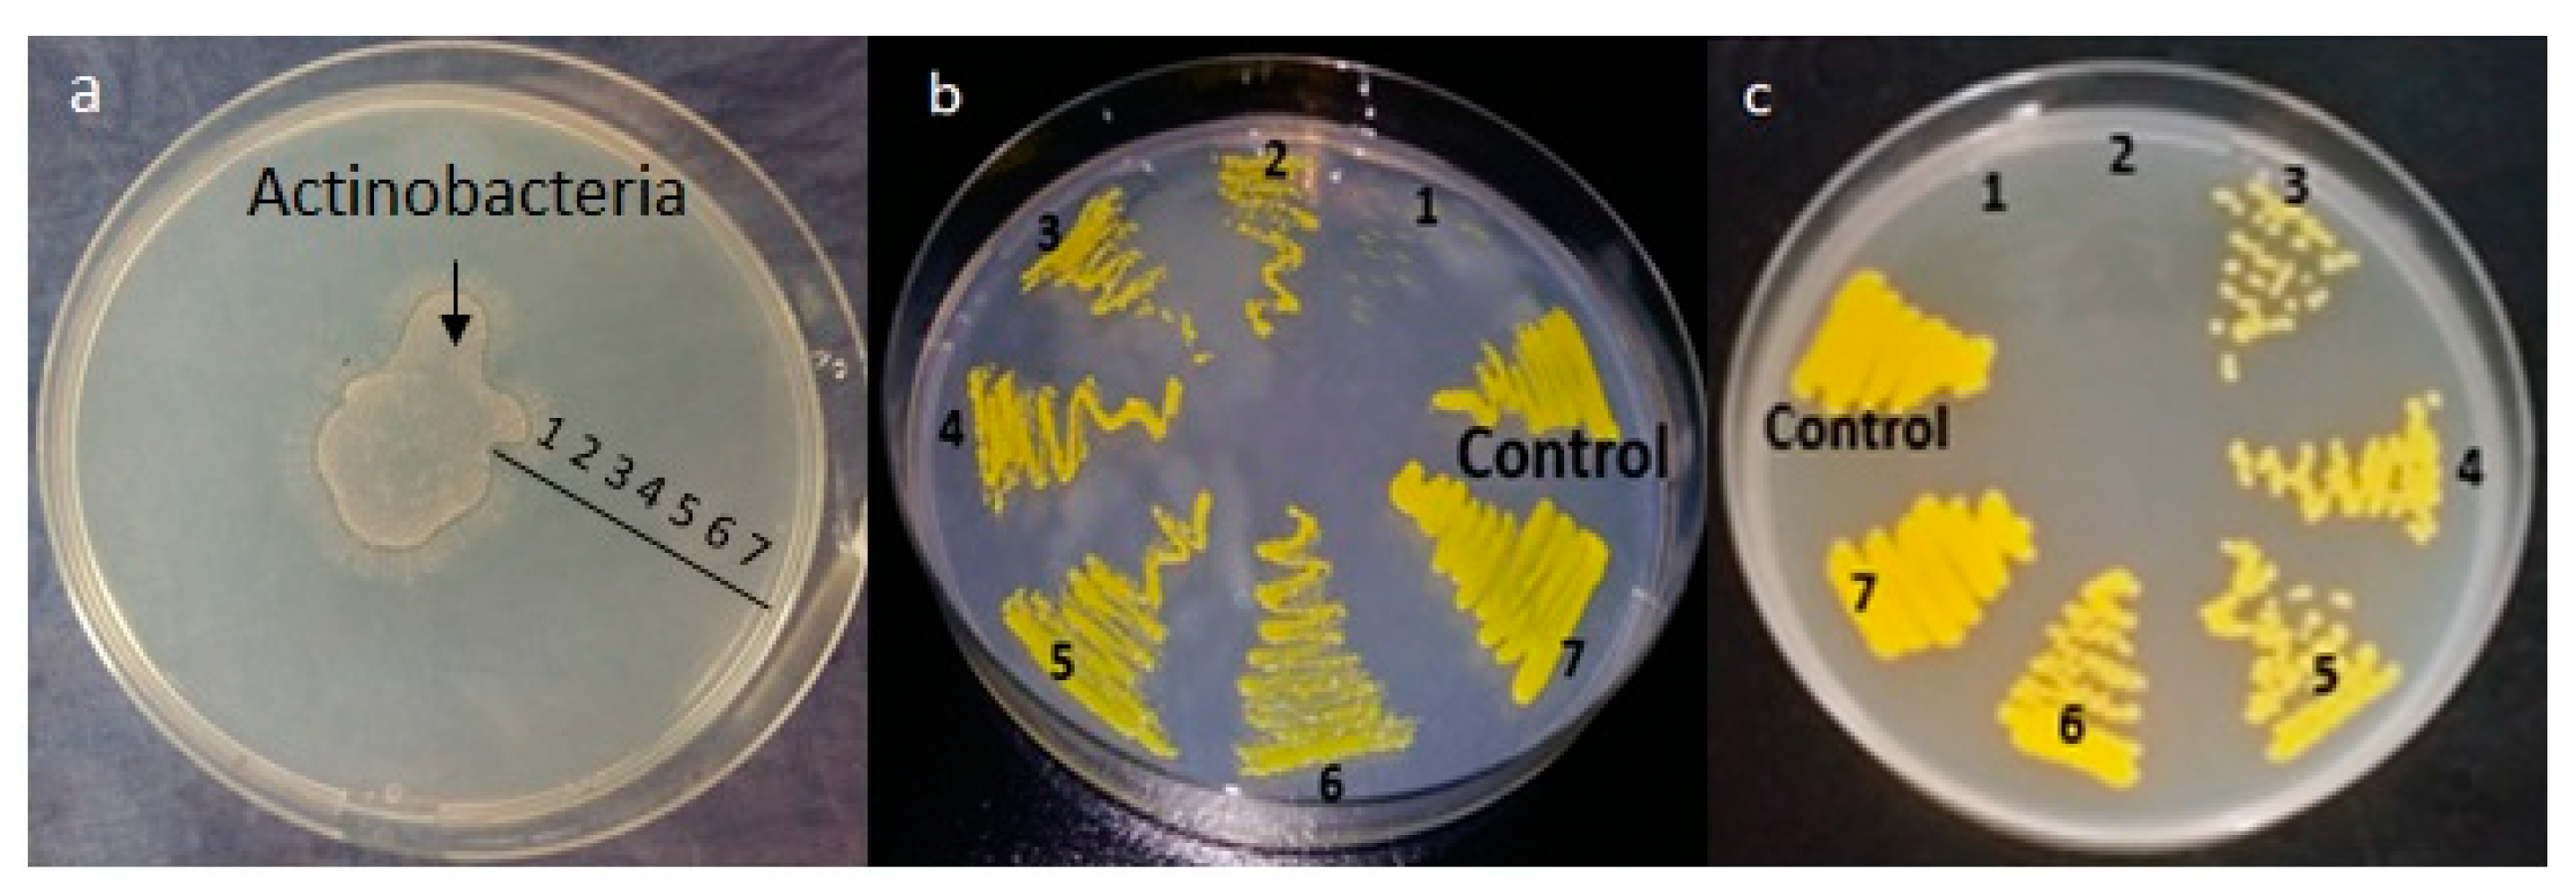

Marine Actinobacteria: Screening for Predation Leads to the Discovery of Potential New Drugs against Multidrug-Resistant Bacteria
Abstract
1. Introduction
2. Results
2.1. Physico-Chemical Parameters
2.2. Isolation and Screening of Predatory Actinobacteria
2.3. Selection of Actinobacteria with Predatory Ability and Assessement of the Putative Prey Specificity of the Selected Actinobacteria Predators
2.4. Impact of Actinobacteria on M. Luteus Viability
2.5. Production of Antimicrobial Compounds by Actinobacteria Grown on Bennett Medium
2.6. Morphological, Physiological, and Molecular Characterization of the Selected Facultative Predator Actinobacteria Isolates
3. Discussion
4. Conclusions
5. Materials and Methods
5.1. Samples and Microbial Strains
5.1.1. Sample Collection
5.1.2. Bacterial Strains
5.2. Preparation of the Prey Cells and Screening of Predatory Actinobacteria Potential
5.3. Selection of Actinobacteria with Predatory Ability and Assessement of the Putative Prey Specificity of the Selected Actinobacteria Predators
5.4. Impact of Actinobacteria on M. Luteus Viability
5.5. Production of Antimicrobial Compounds by Actinobacteria Grown on Bennett Medium
5.6. Statistical Analysis
5.7. Morphological, Physiological, and Molecular Characterization of the Selected Facultative Predator Actinobacteria Isolates
Supplementary Materials
Author Contributions
Funding
Acknowledgments
Conflicts of Interest
References
- Avorn, J.L.; Barrett, J.F.; Davey, P.G.; McEwen, S.A.; O’Brien, T.F.; Levy, S.B. Response, World Health Organization Dept of Epidemic and Pandemic Alert and Alliance for the Prudent Use of Antibiotic. In Antibiotic Resistance: Synthesis of Recommendations by Expert Policy Group; World Health Organization: Geneva, Switzerland, 2001. [Google Scholar]
- Cragg, G.M.; Grothaus, P.G.; Newman, D.J. Impact of natural products on developing new anti-cancer agents. Chem. Rev. 2009, 109, 3012–3043. [Google Scholar] [CrossRef]
- Coates, A.R.; Halls, G.; Hu, Y. Novel classes of antibiotics or more of the same? Br. J. Pharm. 2011, 163, 184–194. [Google Scholar] [CrossRef]
- Demerec, M. Origin of Bacterial Resistance to Antibiotics. J. Bacteriol. 1948, 56, 63. [Google Scholar] [CrossRef]
- Lieberman, J.M. Appropriate antibiotic use and why it is important: The challenges of bacterial resistance. Pediatri. Infect. Dis. J. 2003, 22, 1143–1151. [Google Scholar] [CrossRef]
- Lorcy, A.; Dubé, E. Les enjeux des bactéries multi-résistantes à l’hôpital. Innovations technologiques, politiques publiques et expériences du personnel. Anthropologie & Santé. Revue Internationale Francophone D’anthropologie de la Santé 2018. [Google Scholar] [CrossRef]
- Furusawa, C.; Horinouchi, T.; Maeda, T. Toward prediction and control of antibiotic-resistance evolution. Curr. Opin. Biotechnol. 2018, 54, 45–49. [Google Scholar] [CrossRef] [PubMed]
- Sarkar, R.; Paul, R.; Roy, D.; Thakur, I.; Ray, J.; Sau, T.J.; Haldar, K.; Mondal, J. Rising levels of antibiotic resistance in bacteria: A cause for concern. J. Assoc. Physicians India 2017, 65, 107. [Google Scholar] [PubMed]
- Van der Meij, A.; Worsley, S.F.; Hutchings, M.I.; Van Wezel, G.P. Chemical ecology of antibiotic production by actinomycetes. FEMS Microbiol. Rev. 2017, 41, 392–416. [Google Scholar] [CrossRef]
- Kavitha, A.; Vijayalakshmi, M.; Sudhakar, P.; Narasimha, G. Screening of actinomycetes strains for the production of antifungal metabolites. AJMR 2010, 4, 027–032. [Google Scholar]
- Ouchari, L.; Boukeskasse, A.; Bouizgarne, B.; Ouhdouch, Y. Antimicrobial potential of actinomycetes isolated from the unexplored hot Merzouga desert and their taxonomic diversity. Biol. Open 2019, 8, bio035410. [Google Scholar] [CrossRef]
- Ortiz-Ortiz, L.; Bojalil, L.F.; Yakoleff, V. Biological, Biochemical, and Biomedical Aspects of Actinomycetes; Elsevier: Amsterdam, The Netherlands, 2013; ISBN 978-1-4832-7369-3. [Google Scholar]
- Abdelmohsen, U.R.; Grkovic, T.; Balasubramanian, S.; Kamel, M.S.; Quinn, R.J.; Hentschel, U. Elicitation of secondary metabolism in actinomycetes. Biotechnol. Adv. 2015, 33, 798–811. [Google Scholar] [CrossRef]
- Arul Jose, P.; Jebakumar, S.R.D. Non-streptomycete actinomycetes nourish the current microbial antibiotic drug discovery. Front. Microbiol. 2013, 4, 240. [Google Scholar]
- Baltz, R.H. Natural product drug discovery in the genomic era: Realities, conjectures, misconceptions, and opportunities. J. Ind. Microbiol. Biotechnol. 2019, 46, 281–299. [Google Scholar] [CrossRef] [PubMed]
- Ikeda, H.; Shin-ya, K.; Omura, S. Genome mining of the Streptomyces avermitilis genome and development of genome-minimized hosts for heterologous expression of biosynthetic gene clusters. J. Ind. Microbiol. Biotechnol. 2014, 41, 233–250. [Google Scholar] [CrossRef]
- Olano, C.; García, I.; González, A.; Rodriguez, M.; Rozas, D.; Rubio, J.; Sánchez-Hidalgo, M.; Braña, A.F.; Méndez, C.; Salas, J.A. Activation and identification of five clusters for secondary metabolites in Streptomyces albus J1074. Microb. Biotechnol. 2014, 7, 242–256. [Google Scholar] [CrossRef] [PubMed]
- Scherlach, K.; Hertweck, C. Triggering cryptic natural product biosynthesis in microorganisms. Org. Biomol. Chem. 2009, 7, 1753–1760. [Google Scholar] [CrossRef]
- Dashti, Y.; Grkovic, T.; Abdelmohsen, U.; Hentschel, U.; Quinn, R. Production of induced secondary metabolites by a co-culture of sponge-associated actinomycetes, Actinokineospora sp. EG49 and Nocardiopsis sp. RV163. Mar. Drugs 2014, 12, 3046–3059. [Google Scholar] [CrossRef]
- Sung, A.; Gromek, S.; Balunas, M. Upregulation and identification of antibiotic activity of a marine-derived Streptomyces sp. via co-cultures with human pathogens. Mar. Drugs 2017, 15, 250. [Google Scholar] [CrossRef] [PubMed]
- Vikeli, E.; Widdick, D.A.; Batey, S.F.; Heine, D.; Holmes, N.A.; Bibb, M.J.; Martins, D.J.; Pierce, N.E.; Hutchings, M.I.; Wilkinson, B. In situ activation and heterologous production of a cryptic lantibiotic from a plant-ant derived Saccharopolyspora species. Appl. Environ. Microbiol. 2019. [Google Scholar] [CrossRef]
- Hoshino, S.; Onaka, H.; Abe, I. Activation of silent biosynthetic pathways and discovery of novel secondary metabolites in actinomycetes by co-culture with mycolic acid-containing bacteria. J. Ind. Microbiol. Biotechnol. 2019, 46, 363–374. [Google Scholar] [CrossRef]
- Pettit, R.K. Mixed fermentation for natural product drug discovery. Appl. Microbiol. Biotechnol. 2009, 83, 19–25. [Google Scholar] [CrossRef] [PubMed]
- Ueda, K.; Beppu, T. Antibiotics in microbial coculture. J. Antibiot. 2017, 70, 361. [Google Scholar] [CrossRef] [PubMed]
- Xiao, Y.; Wei, X.; Ebright, R.; Wall, D. Antibiotic production by myxobacteria plays a role in predation. J. Bacteriol. 2011, 193, 4626–4633. [Google Scholar] [CrossRef]
- Korp, J.; Gurovic, M.S.V.; Nett, M. Antibiotics from predatory bacteria. Beilstein J. Org. Chem. 2016, 12, 594–607. [Google Scholar] [CrossRef]
- Jurkevitch, E. Predatory behaviors in bacteria-diversity and transitions. Microbe Am. Soc. Microbiol. 2007, 2, 67. [Google Scholar] [CrossRef]
- Casida, L.E., Jr. Ensifer adhaerens gen. nov., sp. nov.: A bacterial predator of bacteria in soil. Int. J. Syst. Evol. Microbiol. 1982, 32, 339–345. [Google Scholar] [CrossRef]
- Kreutzer, M.F.; Kage, H.; Nett, M. Structure and biosynthetic assembly of cupriachelin, a photoreactive siderophore from the bioplastic producer Cupriavidus necator H16. J. Am. Chem. Soc. 2012, 134, 5415–5422. [Google Scholar] [CrossRef]
- Makkar, N.S.; Casida, L.E., Jr. Cupriavidus necator gen. nov., sp. nov.; a Nonobligate Bacterial Predator of Bacteria in Soil. Int. J. Syst. Evol. Microbiol. 1987, 37, 323–326. [Google Scholar] [CrossRef]
- Li, S.; Jochum, C.C.; Yu, F.; Zaleta-Rivera, K.; Du, L.; Harris, S.D.; Yuen, G.Y. An antibiotic complex from Lysobacter enzymogenes strain C3: Antimicrobial activity and role in plant disease control. Phytopathology 2008, 98, 695–701. [Google Scholar] [CrossRef]
- Seccareccia, I.; Kost, C.; Nett, M. Quantitative Analysis of Lysobacter Predation. Appl. Environ. Microbiol. 2015, 81, 7098–7105. [Google Scholar] [CrossRef]
- Baig, U.I.; Pund, A.; Holkar, K.; Watve, M. Predator prey and the third beneficiary. bioRxiv 2019, 730895. [Google Scholar] [CrossRef]
- Berleman, J.E.; Kirby, J.R. Deciphering the hunting strategy of a bacterial wolfpack. FEMS Microbiol. Rev. 2009, 33, 942–957. [Google Scholar] [CrossRef] [PubMed]
- Reichenbach, H.; Höfle, G. Biologically active secondary metabolites from myxobacteria. Biotechnol. Adv. 1993, 11, 219–277. [Google Scholar] [CrossRef]
- Schieferdecker, S.; König, S.; Weigel, C.; Dahse, H.-M.; Werz, O.; Nett, M. Structure and Biosynthetic Assembly of Gulmirecins, Macrolide Antibiotics from the Predatory Bacterium Pyxidicoccus fallax. Chem. Eur. J. 2014, 20, 15933–15940. [Google Scholar] [CrossRef] [PubMed]
- Kohl, W.; Irschik, H.; Reichenbach, H.; Höfle, G. Antibiotika aus Gleitenden Bakterien, XVII. Myxopyronin A und B—Zwei neue Antibiotika aus Myxococcus fulvus Stamm Mx f50. Liebigs Ann. Chem. 1983, 1983, 1656–1667. [Google Scholar] [CrossRef]
- Irschik, H.; Jansen, R.; Höfle, G.; Gerth, K.; Reichenbach, H. The corallopyronins, new inhibitors of bacterial RNA synthesis from Myxobacteria. J. Antibiot. 1985, 38, 145–152. [Google Scholar] [CrossRef]
- Schäberle, T.F.; Schmitz, A.; Zocher, G.; Schiefer, A.; Kehraus, S.; Neu, E.; Roth, M.; Vassylyev, D.G.; Stehle, T.; Bierbaum, G.; et al. Insights into Structure–Activity Relationships of Bacterial RNA Polymerase Inhibiting Corallopyronin Derivatives. J. Nat. Prod. 2015, 78, 2505–2509. [Google Scholar] [CrossRef]
- Kunze, B.; Reichenbach, H.; Augustiniak, H.; Höfle, G. Isolation and identification of althiomycin from Cystobacter fuscus (Myxobacterales). J. Antibiot. 1982, 35, 635–636. [Google Scholar] [CrossRef]
- Waksman, S.A.; Woodruff, H.B. Actinomyces antibioticus, a new soil organism antagonistic to pathogenic and non-pathogenic bacteria. J. Bacteriol. 1941, 42, 231. [Google Scholar] [CrossRef]
- Kumbhar, C.; Mudliar, P.; Bhatia, L.; Kshirsagar, A.; Watve, M. Widespread predatory abilities in the genus Streptomyces. Arch. Microbiol. 2014, 196, 235–248. [Google Scholar] [CrossRef]
- Banning, E.C.; Casciotti, K.L.; Kujawinski, E.B. Novel strains isolated from a coastal aquifer suggest a predatory role for Flavobacteria. FEMS Microbiol. Ecol. 2010, 73, 254–270. [Google Scholar] [CrossRef] [PubMed]
- Banning, E.C. Biology and Potential Biogeochemical Impacts of Novel Predatory Flavobacteria; DTIC Document; Massachusetts Institute of Technology: Cambridge, MA, USA, 2010. [Google Scholar]
- Subramani, R.; Aalbersberg, W. Marine actinomycetes: An ongoing source of novel bioactive metabolites. Microbiol. Res. 2012, 167, 571–580. [Google Scholar] [CrossRef] [PubMed]
- Subramani, R.; Sipkema, D. Marine rare actinomycetes: A promising source of structurally diverse and unique novel natural products. Mar. Drugs 2019, 17, 249. [Google Scholar] [CrossRef] [PubMed]
- Rouhi, A.; Sif, J.; Ferssiwi, A.; Gillet, P.; Deutch, B. Reproduction and population dynamics of Perinereis cultrifera (Polychaeta: Nereididae) of the Atlantic coast, El Jadida, Morocco. Cahiers de Biologie Marine 2008, 49, 151. [Google Scholar]
- Benchoucha, S.; Berraho, A.; Bazairi, H.; Katara, I.; Benchrifi, S.; Valavanis, V.D. Salinity and temperature as factors controlling the spawning and catch of Parapenaeus longirostris along the Moroccan Atlantic Ocean. In Essential Fish Habitat Mapping in the Mediterranean; Springer: Berlin/Heidelberg, Germany, 2008; pp. 109–123. [Google Scholar]
- Shirling, E.T.; Gottlieb, D. Methods for characterization of Streptomyces species. Int. J. Syst. Evol. Microbiol. 1966, 16, 313–340. [Google Scholar] [CrossRef]
- Ibrahimi, M.; Korichi, W.; Loqman, S.; Hafidi, M.; Ouhdouch, Y.; Lemee, L. Thermochemolysis–GC-MS as a tool for chemotaxonomy and predation monitoring of a predatory Actinobacteria against a multidrug resistant bacteria. J. Anal. Appl. Pyrolysis 2019, 145, 104740. [Google Scholar] [CrossRef]
- Singh, B.N. Myxobacteria in soils and composts; their distribution, number and lytic action on bacteria. Microbiology 1947, 1, 1–10. [Google Scholar] [CrossRef]
- Sangkhobol, V.; Skerman, V.B. Saprospira species—Natural predators. Curr. Microbiol. 1981, 5, 169–174. [Google Scholar] [CrossRef]
- McBride, M.J.; Zusman, D.R. Behavioral analysis of single cells of Myxococcus xanthus in response to prey cells of Escherichia coli. FEMS Microbiol. Lett. 1996, 137, 227–231. [Google Scholar] [CrossRef]
- Jurkevitch, E. Predatory Prokaryotes: Biology, Ecology and Evolution; Springer Science & Business Media: Berlin, Germany, 2006; Volume 4. [Google Scholar]
- Markelova, N.Y. Predacious bacteria, Bdellovibrio with potential for biocontrol. Int. J. Hyg. Environ. Health 2010, 213, 428–431. [Google Scholar] [CrossRef]
- Fratamico, P.M.; Cooke, P.H. Isolation of Bdellovibrios that prey on Escherichia coli O157: H7 and Salmonella species and application for removal of prey from stainless steel surfaces. J. Food Saf. 1996, 16, 161–173. [Google Scholar] [CrossRef]
- Sockett, R.E.; Lambert, C. Bdellovibrio as therapeutic agents: A predatory renaissance? Nat. Rev. Microbiol. 2004, 2, 669–675. [Google Scholar] [CrossRef] [PubMed]
- Schisler, D.A.; Khan, N.I.; Boehm, M.J.; Slininger, P.J. Greenhouse and field evaluation of biological control of Fusarium head blight on durum wheat. Plant Dis. 2002, 86, 1350–1356. [Google Scholar] [CrossRef] [PubMed]
- Casida, L.E. Minireview: Nonobligate bacterial predation of bacteria in soil. Microb. Ecol. 1988, 15, 1–8. [Google Scholar] [CrossRef]
- Casida, L.E. Bacterial predators of Micrococcus luteus in soil. Appl. Environ. Microbiol. 1980, 39, 1035–1041. [Google Scholar] [CrossRef]
- Othman, B.A.; Askora, A.; Awny, N.M.; Abo-Senna, A.S.M. Characterization of virulent bacteriophages for Streptomyces griseoflavus isolated from soil. Pak. J. Biotechnol. 2008, 5, 109–119. [Google Scholar]
- Hassan, R.; Shaaban, M.I.; Abdel Bar, F.M.; El-Mahdy, A.M.; Shokralla, S. Quorum sensing inhibiting activity of Streptomyces coelicoflavus isolated from soil. Front. Microbiol. 2016, 7, 659. [Google Scholar] [CrossRef]
- Belghit, S.; Driche, E.H.; Bijani, C.; Zitouni, A.; Sabaou, N.; Badji, B.; Mathieu, F. Activity of 2,4-Di-tert-butylphenol produced by a strain of Streptomyces mutabilis isolated from a Saharan soil against Candida albicans and other pathogenic fungi. J. Mycol. Médicale 2016, 26, 160–169. [Google Scholar] [CrossRef]
- Pesic, A.; Baumann, H.; Kleinschmidt, K.; Ensle, P.; Wiese, J.; Süssmuth, R.; Imhoff, J. Champacyclin, a new cyclic octapeptide from Streptomyces strain C42 isolated from the Baltic Sea. Mar. Drugs 2013, 11, 4834–4857. [Google Scholar] [CrossRef]
- Okazai, T. Actinomycetes tolerant to increased NaCl concentration and their metabolites. J. Ferment. Technol. 1975, 53, 833–840. [Google Scholar]
- Goodfellow, M.; Williams, S.T. Ecology of actinomycetes. Annu. Rev. Microbiol. 1983, 37, 189–216. [Google Scholar] [CrossRef] [PubMed]
- Shomura, T.; Yoshida, J.; Amano, S.; Kojima, M.; Inouye, S.; Niida, T. Studies on Actinomycetales producing antibiotics only on agar culture. J. Antibiot. 1979, 32, 427–435. [Google Scholar] [CrossRef] [PubMed]
- Wayne, P.A. Performance Standards for Antimicrobial Susceptibility Testing; Twenty-First Informational Supplement, CLSI Document M100-S21; Clinical and Laboratory Standards Institute: Wayne, PA, USA, 2011. [Google Scholar]
- Hopwood, D.A. Genetic Manipulation of Streptomyces: A Laboratory Manual; John Innes Foundation: Norwich, UK; Cold Spring Harbour Laboratory: New York, NY, USA, 1985. [Google Scholar]

| Samples | Number of Predatory Bacteria | Number of Predatory Actinobacteria | Method of Isolation | Code |
|---|---|---|---|---|
| 1 | 23 | 2 | 2 | EMM111 |
| 1 | EMM112 | |||
| 2 | 12 | 1 | 1 | EMM111 |
| 3 | 17 | 1 | 1 | EMM111 |
| 4 | 6 | 1 | 1 | EMM111 |
| 5 | 11 | 0 | - | - |
| 6 | 5 | 1 | 1 | EMM111 |
| 7 | 18 | 1 | 1 | EMM111 |
| 8 | 30 | 1 | 2 | EMM183 |
| 9 | 20 | 1 | 2 | EMM194 |
| Strains | Predatory Activity | Antibacterial Activity in a Rich Medium (Bennett) | ||||||||
|---|---|---|---|---|---|---|---|---|---|---|
| ML | SA | EC | MRSA | AREC | ML | SA | EC | MRSA | AREC | |
| EMM111 | + | + | + | + | + | 22.16 ± 0.7 | 17.5 ± 0.5 | 0 | 16.3 | 0 |
| EMM112 | + | + | + | + | + | 45 ± 1 | 35.4 ± 0.9 | 23 ± 1 | 34.6 ± 0.5 | 15 ± 1 |
| EMM183 | + | + | + | + | + | 0 | 35 ± 1 | 0 | 23.26 ± 3.2 | 0 |
| EMM194 | + | + | + | + | + | 0 | 0 | 4.4 ± 0.5 | 0 | 0 |
| Properties | EMM111 | EMM112 | EMM183 | EMM194 |
|---|---|---|---|---|
| ISP2 | ||||
| Color of aerial mycelium | beige | orange | white | white |
| Color of substrate mycelium | white | brown | beige | white |
| Diffusible pigment produced | orange | - | brown | - |
| ISP6 | ||||
| Color of aerial mycelium | beige | grey | white | white |
| Color of substrate mycelium | beige | black | white | white |
| Diffusible pigment produced | - | - | - | - |
| ISP7 | ||||
| Color of aerial mycelium | beige | grey | pink | white |
| Color of substrate mycelium | white | black | pink | brown |
| Diffusible pigment produced | grey | - | - | - |
| Strains | Percentage of Sequence Identity (%) | Actinobacteria Strains | Accession |
|---|---|---|---|
| EMM111 | 99 | Streptomyces griseoflavus | NR_042291.1 |
| EMM112 | 100 | Streptomyces coelicoflavus | NR_041175.1 |
| EMM183 | 100 | Streptomyces mutabilis | NR_044139.1 |
| EMM194 | 99 | Streptomyces champavatii | NR_115669.1 |
© 2020 by the authors. Licensee MDPI, Basel, Switzerland. This article is an open access article distributed under the terms and conditions of the Creative Commons Attribution (CC BY) license (http://creativecommons.org/licenses/by/4.0/).
Share and Cite
Ibrahimi, M.; Korichi, W.; Hafidi, M.; Lemee, L.; Ouhdouch, Y.; Loqman, S. Marine Actinobacteria: Screening for Predation Leads to the Discovery of Potential New Drugs against Multidrug-Resistant Bacteria. Antibiotics 2020, 9, 91. https://doi.org/10.3390/antibiotics9020091
Ibrahimi M, Korichi W, Hafidi M, Lemee L, Ouhdouch Y, Loqman S. Marine Actinobacteria: Screening for Predation Leads to the Discovery of Potential New Drugs against Multidrug-Resistant Bacteria. Antibiotics. 2020; 9(2):91. https://doi.org/10.3390/antibiotics9020091
Chicago/Turabian StyleIbrahimi, Manar, Wassila Korichi, Mohamed Hafidi, Laurent Lemee, Yedir Ouhdouch, and Souad Loqman. 2020. "Marine Actinobacteria: Screening for Predation Leads to the Discovery of Potential New Drugs against Multidrug-Resistant Bacteria" Antibiotics 9, no. 2: 91. https://doi.org/10.3390/antibiotics9020091
APA StyleIbrahimi, M., Korichi, W., Hafidi, M., Lemee, L., Ouhdouch, Y., & Loqman, S. (2020). Marine Actinobacteria: Screening for Predation Leads to the Discovery of Potential New Drugs against Multidrug-Resistant Bacteria. Antibiotics, 9(2), 91. https://doi.org/10.3390/antibiotics9020091

